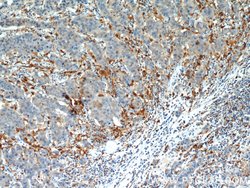
CAPG Rabbit anti-Human, Mouse, Rat, Polyclonal, Proteintech:Antibodies:Primary

missing translation for 'onlineSavingsMsg'
Learn More
Learn More
CAPG Rabbit anti-Human, Mouse, Rat, Polyclonal, Proteintech
Rabbit Polyclonal Antibody
£135.00 - £349.00
Specifications
| Antigen | CAPG |
|---|---|
| Concentration | 0.2 mg/mL |
| Applications | Immunoprecipitation, Immunohistochemistry (Paraffin), Immunofluorescence, Immunocytochemistry, Western Blot |
| Classification | Polyclonal |
| Conjugate | Unconjugated |
| Product Code | Brand | Quantity | Price | Quantity & Availability | |||||
|---|---|---|---|---|---|---|---|---|---|
| Product Code | Brand | Quantity | Price | Quantity & Availability | |||||
|
16866413
|
Proteintech
10194-1-AP-20UL |
20 μL |
£135.00
20µL |
Please sign in to purchase this item. Need a web account? Register with us today! | |||||
|
16856413
|
Proteintech
10194-1-AP-150UL |
150 μL |
£349.00
150µL |
Please sign in to purchase this item. Need a web account? Register with us today! | |||||
Description
This gene encodes a member of the gelsolin/villin family of actin-regulatory proteins. The encoded protein reversibly blocks the barbed ends of F-actin filaments in a Ca2+ and phosphoinositide-regulated manner, but does not sever preformed actin filaments. By capping the barbed ends of actin filaments, the encoded protein contributes to the control of actin-based motility in non-muscle cells. Alternatively spliced transcript variants have been observed, but have not been fully described.Specifications
| CAPG | |
| Immunoprecipitation, Immunohistochemistry (Paraffin), Immunofluorescence, Immunocytochemistry, Western Blot | |
| Unconjugated | |
| Rabbit | |
| Human, Rat, Mouse | |
| P24452, P40121, Q6AYC4 | |
| 12332, 297339, 822 | |
| CAPG Fusion Protein Ag0248 | |
| Primary | |
| -20°C | |
| CAPG |
| 0.2 mg/mL | |
| Polyclonal | |
| Liquid | |
| RUO | |
| PBS with 50% glycerol and 0.1% sodium azide; pH 7.3 | |
| Actin regulatory protein CAP G, AFCP, CAPG, Macrophage capping protein, MCP | |
| CAPG | |
| IgG | |
| Antigen Affinity Chromatography | |
| Antibody |
Spot an opportunity for improvement?Share a Content Correction
Product Content Correction
Your input is important to us. Please complete this form to provide feedback related to the content on this product.
Product Title